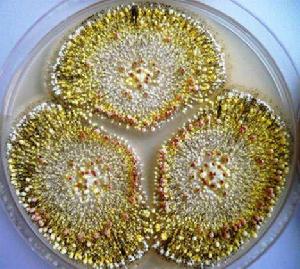
黴菌毒素物理脫毒 黴菌毒素物理脫毒

黴菌毒素物理脫毒簡介
黴菌毒素的物理脫毒方法主要包括有機溶劑的浸提、熱處理、射線處理和無機吸附劑吸附等。黃麴黴毒素在加熱的條件下具有很強的穩定性,因此,蒸煮、微波和烘烤等熱處理對黃麴黴毒素沒有明顯的破壞作用。射線處理可以明顯降低飼料中黃麴黴毒素的含量。馮定遠(1995)發現日光照射處理花生餅可以顯著降低其中的黃麴黴毒素。Park和Liang(1993)發現短波和長波紫外光可以顯著降低花生油中黃麴黴毒素的水平;日光照射14h也可以降低花生薄片中50%的黃麴黴毒素;同時還發現,一些有機溶劑也可以減少樣品中黃麴黴毒素的含量而並不明顯影響樣品中的營養品質和蛋白質含量,這類有機溶劑包括95%乙醇、90%丙酮、80%異丙醇、80%己烷、乙醇、80%己烷一甲醛和80%己烷一丙酮。
物理脫毒基本方法介紹
無機黴菌毒素吸附劑
無機黴菌毒素吸附劑是通過其特殊的物理結構和性質與黴菌毒素形成穩定的複合物,降低動物腸道和機體對各種黴菌毒素的吸收,從而降低黴菌毒素對動物的毒害作用。目前,在飼料中使用的無機黴菌毒素吸附劑主要有水合矽鋁酸鈣鈉鹽、沸石、膨潤土、粘土和活性炭。但吸附劑的種類、來源和理化性質的不同,對黴菌毒素的吸附能力也有所不同,其動物黴菌毒素中毒的防治效果也有所不同。
活性炭
活性炭是一種具有高度微孔結構的有機物炭化產物。活性炭對黴菌毒素的吸附作用與其來源、物理性質(如表面積和孔徑分布)有關。活性炭對黴菌毒素的吸附作用並不受胃腸道內環境如pH值等的影響,但是其對於消化道中的營養物質也有一定的吸附作用。Jindal等(1994)在含500μg/kg黃麴黴毒素B1的飼料中添加200mg/kg的活性炭,結果消除了黃麴黴毒素對肉雞生長的不良影響。但也有報導指出活性炭對黃麴黴毒素的吸附沒有正面作用。另外,當飼料中添加活性炭後,飼料和動物糞便顏色變黑,給養殖生產帶來一定的不便之處。
沸石
沸石是一種多孔矽鋁酸鹽礦物質,基本結構是矽氧四面體,矽氧四面體中的四價矽離子可被三價鋁離子取代形成鋁氧四面體,並帶有一個單位負電荷。沸石具有較大的比表面積,因而具有巨大的表面能,同時沸石的四面體表面及層間都具有永久負電荷,能產生較大的靜電引力,因此沸石具有巨大的吸附能力。
HSCAS是一種天然沸石嗜矽衍生物,對黃麴黴毒素具有很高的特異性,能夠與黃麴黴毒素形成穩定的複合物。Phillips等(1988)在含有7.5mg/kg黃麴黴毒素B1的飼料中添加0.5%的HSCAS,結果降低了黃麴黴毒素B1對雞的毒害作用,對肝臟損傷也具有一定的修復作用。Kubena等(1990)在同時含有黃麴黴毒素和赭麴黴毒素(或T-2毒素)的飼料中添加HSCAS,結果發現HSCAS僅僅對黃麴黴毒素有保護作用,對赭麴黴毒素和T-2毒素的保護作用很小。試驗也表明,HSCAS對蛇形毒素的結合能力也較差,且HSCAS在動物胃腸道中的環境中容易與黃麴黴毒素以外的各種毒素分開,降低了其對黴菌毒素的吸附作用。
HSCAS對黃麴黴毒素有很高的特異性,這主要與其結構有關。HSCAS具有相對較強的剛性且幾乎呈片面排列的原子結構,其分子中含有1,3雙酮結構,分子中的金屬離子與黃麴黴毒素中的β—酮一內酯或二內酯可以形成穩定的複合物。儘管嘔吐毒素和T-2毒素也具有剛性的分子結構,但是其分子的環狀構造使其沒有同面性,而玉米赤黴毒素的部分結構雖然具有同面性的酚環,但是其他部分結構非常鬆弛,因此,與HSCAS的結合能力較弱。
赭麴黴毒素A的物理脫毒
物理脫毒法是利用清洗除塵、研磨洗擦、吸附、輻照等手段達到減少或脫毒的效果。但清洗剔除的霉粒處理不當還會對環境造成二次污染;通過吸附只是將毒素轉移並沒有將毒素破壞或者降解;γ射線輻照,雖能保證其主要營養成分和感官不變,尤其在水溶液里,降解率能達到90%,但是不易操作,設備和放射源控制等都需要較高要求。食品原料和飼料生產中套用較多的物質是活性炭,早在1998年,Galvano等人證明活性炭能夠對真菌毒素進行較好的吸附,體外脫除OTA效果較好,缺點是專一性不強,例如葡萄酒中活性炭脫除OTA時,對多酚含量和葡萄酒的顏色有影響。
黃麴黴毒素的物理脫毒
凹凸棒土由於具有獨特的三維空間結構和較大的比表面積,同時帶有不飽和負電荷及具有陽離子交換能力,因而具有不同尋常的膠體性質和吸附性能,可用於食品、化工、環境等領域,而且其儲量豐富,價格便宜,可作為黃麴黴毒素Bl(AFB1)的吸附劑。通過選擇凹凸棒土對黃麴黴毒素B1的吸附熱力學和動力學特性進行研究,得出其吸附為簡單的單分子層優惠吸附,屬於二級吸附過程。生產中常採用的方法是在日糧中添加吸附劑來吸附動物消化道內的AF,阻止機體對毒素的吸收,從而降低毒素對動物體的危害和毒素在動物產品中的殘留。
Youjun Deng等研究了班脫土(皂土)用於減少被黃麴黴毒素污染的飼料和食品的真菌毒素生物藥效率(生物利用度)的方法。在乾燥條件下,蒙脫土與黃麴黴毒素B1之間的吸附主要是離子偶極相互作用和可交換陽離子、羰基之間的協調作用。在濕度條件下,蒙脫土與黃麴黴毒素B1之間的吸附主要是可交換陽離子水合作用與羰基之間的氫鍵作用。
物理方法存在效果不穩定、營養成分損失較大以及難以規模化生產等缺點。但是凹凸棒土吸附可以解決大規模生產的問題。目前還有添加黴菌吸附劑的辦法,這種方法在吸附毒素的同時會吸附一些營養成分,也不能徹底去除黃麴黴毒素的毒性,動物生產性能仍然受到很大的影響。